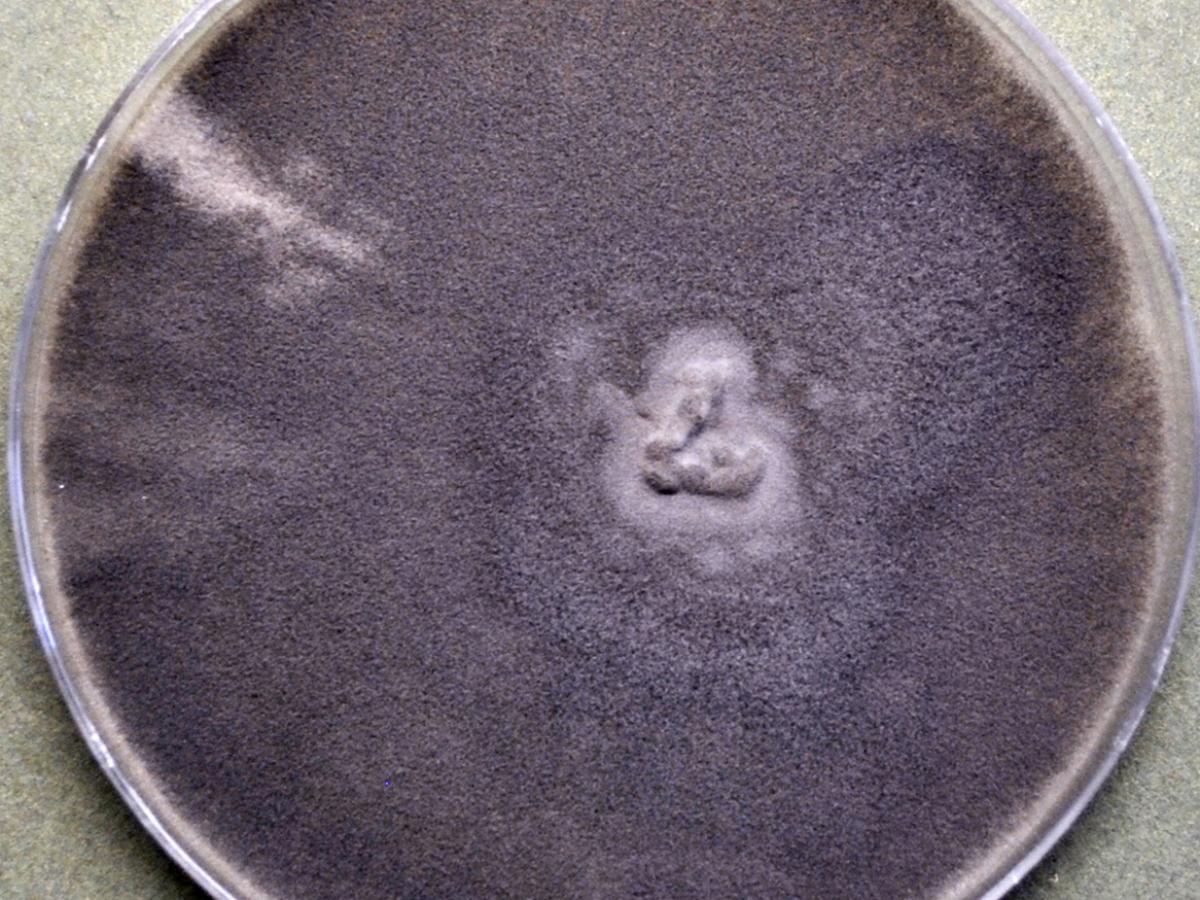
<p>Identify this fungus</p>
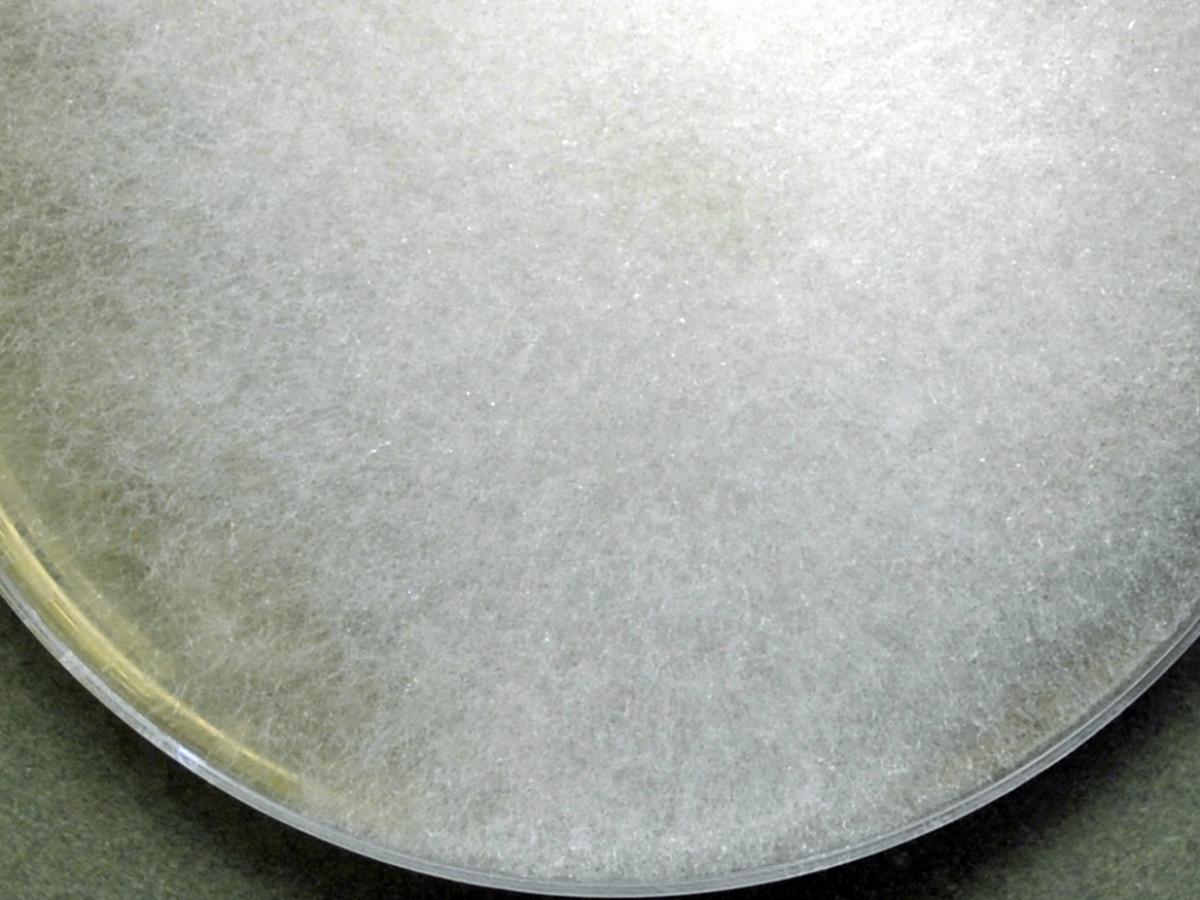
<p>Identify this fungus</p>

MVP 2026 - Mycology Identification
0.0(0)
0.0(0)
Card Sorting
1/17
There's no tags or description
Looks like no tags are added yet.
Study Analytics
Name | Mastery | Learn | Test | Matching | Spaced | Call with Kai |
|---|
No study sessions yet.
18 Terms
1
New cards

Identify this fungus
Rhizopus spp.
2
New cards

Identify this fungus
Rhizopus spp.
3
New cards

Identify this fungus
Rhizopus spp.
4
New cards
Identify this fungus
Mucor spp.
5
New cards

Identify this fungus
Mucor spp.
6
New cards

Identify this fungus
Mucor spp.
7
New cards

Identify this fungus
Mucor spp.
8
New cards

Identify this fungus
Rhizomucor spp.
9
New cards
Identify this fungus
Lichtheimia spp.
10
New cards

Identify this fungus
Lichtheimia spp.
11
New cards

Identify this fungus
Cunninghamella spp.
12
New cards

Identify this fungus
Cunninghamella spp.
13
New cards

Identify this fungus
Cunninghamella spp.
14
New cards

Identify this fungus
Cunninghamella spp.
15
New cards

Identify this fungus
Histoplasma capsulatum
16
New cards

Identify this fungus
Histoplasma capsulatum
17
New cards
Identify this fungus
Blastomyces dermatitidis
18
New cards

Identify this fungus
Blastomycedes dermatitidis